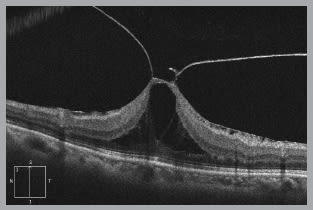
images

posterior
Essential Posterior Segment Diagnostic Technology
Become an expert in retinal evaluation by mastering these devices.
JAY M. HAYNIE, O.D., F.A.A.O., OLYMPIA, WASH.
Given the growing number of diabetic and elderly patients, it’s essential that we have the most up-to-date equipment to sharpen our retinal evaluation skills and knowledge.
For many, the retina is a part of the eye that is a challenge to appreciate. The back of the eye can be difficult to examine, and retina pathology often coexists with other significant patient illness.
Today, new technologies exist to make the evaluation of the posterior segment easier. This creates an opportunity for us to perform more complete evaluations, to expand our services and, most importantly, to provide better care.
Here, I discuss four technologies that all optometrists must master to aid in the diagnosis, evaluation and management of the posterior segment.
Slit lamp
Why is it important?: The initial evaluation of the retina is always undertaken with inspection. The hand held lens at the slit lamp has contributed to something of a revolution in the ability to safely, quickly and comfortably observe the retina.
It is easy to think of the retina as being two dimensional when we look at photographs or use a direct ophthalmoscope. However, in my training in retina, a key point I was taught was the importance of regarding the retina in three dimensions. This is critical to remember, and may take some practice.
This OCT image reveals dramatic vitreomacular traction that is difficult to appreciate through clinical examination or retinal photography.
When you are evaluating a patient who has retinal pathology, the depth of the lesion often aids in making the correct diagnosis. For example: An intraretinal hemorrhage is common with vascular disease, such as diabetes or hypertension, whereas a subretinal hemorrhage is suggestive of choroidal pathology. This is important when you see a hemorrhage near the macula, as a subretinal hemorrhage is more suggestive of AMD and has a far worse prognosis than a hemorrhage from hypertension or diabetes.
Practice pearl: I learned in my training that a 90D lens can be tilted slightly to enhance shadow and a 3-D effect. This creates a dynamic evaluation of the retina, aides in determining the depth of a retinal lesion and enhances surface retinal pathology such as an epiretinal membrane.
Billing: In theory, you cannot bill for a slit lamp evaluation alone. However, when accompanied by a retinal drawing, you may bill for extended ophthalmoscopy (92225 or 92226), a unilateral code.
Ocular coherence tomography (OCT)
Why is it important?: OCT has become an important tool in improving our understanding of both normal and abnormal retinal tissue. The retina is very thin, leading to the natural tendency to think of it as not having significant thickness. An OCT device makes it easy to consider the thickness of the retina as we study our patients. This understanding leads to an increased ability to diagnose certain retinal conditions.
During my retinal fellowship, I learned of the importance of thinking of the retina as having layers, and that different diseases tend to emerge in one layer as opposed to another. Variation in retinal thickness can give a snapshot of how the retinal disease has effected the structure of the retina and choroid. For example: Retinal edema results in an increase thickness of the retina, whereas ischemic-driven disease causes a progressive thinning of the retina. In atrophic AMD your clinical examination of the retina may look surprisingly good. However, with the evolution of AMD the patient develops atrophy of the retinal pigment epithelium, which, in turn, causes a profound thinning of the inner and outer retinal layers as seen with OCT imaging.
Practice pearl: If you have an OCT available, I encourage you to sit with the scan displayed close by as you return to look at the retina itself. In this way, retinal examination skills can be enhanced and correlated with a known image. Clinical correlation is encouraged with all diagnostic instrumentation, and the beauty of OCT images is that you have a map of elevation and pathology that you can appreciate more at the slit lamp.
Billing: Depending on the state in which you practice, there may be a limitation to the number of OCTs you can bill the patient for a given year. More importantly, medical necessity is required (92134).
Indirect ophthalmoscopy
Why is it important?: Indirect ophthalmoscopy can be used to perceive retinal pathology in three dimensions. While there are many indirect ophthalmoscopes, I have come to appreciate the value of their simplicity. Ultimately, any and all types can be used to create quality images. Other factors such as make, weight and comfort are a matter of personal preference.
Practice pearl: An important part of any indirect ophthalmoscopic exam is scleral depression. Scleral depression allows the examiner to move retinal tissue into view that may ordinarily be difficult to examine due to its anterior location in the retina. It also allows us to bring peripheral retinal lesions into profile, aiding in the assessment of overlying vitreous traction. Peripheral retinal degenerations, such as lattice degeneration, have a blanched look to the surrounding tissue under scleral depression, while a pigmented nevus or hypertrophy of the retinal pigment epithelium does not. Pigmented peripheral lesions associated with a risk of a retinal detachment (i.e.: lattice) warrant a discussion with the patient.
My mentor, William Shields, M.D., taught me to perform scleral depression on every new patient unless the retina cannot be seen or there is an unusual circumstance.
As a practical point, there are exceptions: patients with significant pain or phobia may simply not allow this to be done. Additionally, scleral depression should be avoided in patients who have an injured eye, or a possible open globe or the presence of angioid streaks. If you are concerned that a patient may have a ruptured globe, you risk further damage to the globe by performing scleral depression. In addition, angioid streaks are breaks in Bruch’s membrane, and scleral depression may induce hemorrhage or worsen the integrity of the globe.
Billing: In theory you cannot bill for indirect ophthalmoscopy alone. However, when accompanied by a retinal drawing you may bill for extended ophthalmoscopy (92225 or 92226), a unilateral code.
Fundus photography
Why is it important?: Fundus photography has been a helpful tool for retinal disease management for decades. It has been helpful to document findings and to accurately observe change through time. Fundus photography also allows for more leisurely review.
Again, weigh the attributes that are important to you and your practice when purchasing. It can also be a significant source of revenue for our practices.
Practice pearl: Obtaining fundus photography is vital in observing the evolution of retinal disease and becomes useful for follow-up evaluations as a comparison. I encourage red free photography in all patients as it enhances the retinal vasculature and retinal hemorrhages and micro aneurysms become easier to visualize.
Billing: Use 92250, a bilateral code. This requires medical necessity.
Practice makes perfect
Naturally, using any of these tools takes practice. Anyone who wants to gain more of a sense of ease with these tools should consider the following:
1. Give yourself the freedom to say you are learning. You may feel awkward or even clumsy at first; this is normal.
2. Remember it may not be possible to see everything all the time. We find that when we teach some of these skills, it sometimes feels like “I couldn't see things, so the reason must be me.” It may be helpful to keep in mind, however, that after thousands of retinal exams we can honestly say we can’t always see everything either: patients may move, blood may be in the way, or it may not be possible to get a patient into a good position or comfortable. The important thing is to try.
3. Practice in any way you can, and keep it up.
4. Finally, remember that there is no real endpoint in acquiring these skills. There is always something new to learn, and there is always something new to be seen. Rather than viewing this as a source of frustration (“I never get there”) our attitude has been one of celebrating that the journey never ends.
| TECHNOLOGY ARTICLES |
|---|
| JANUARY 2013 Update on EHR • page 44 FEBRUARY 2013 Anterior segment equipment • page 60 APRIL 2013 HR technology |
Moving forward
The images that we obtain with these devices are monumental for patient education and educating the community of doctors who share in the care of our patients. For example: Internal medicine doctors and endocrinologists rely on the ophthalmic examination to determine a state of systemic disease. Some providers even send retinal images to these providers as a part of marketing efforts.
How we evaluate patients today is different in some ways from how we did so in the past. Ultimately, this is a function of increased knowledge, accelerated by technologies that allow us to see more, do more and offer more.
The retina is the part of the eye that actually begins to process what our patients see. It is critical to the clinical experience of our patients, and therefore is an important part of our practices. OM

|
Dr. Haynie is the executive director at Retina & Macula Specialists in Olympia, Wash. E-mail him at JayH@retina-macula.com, or send comments to optometricmanagement@gmail.com. |



